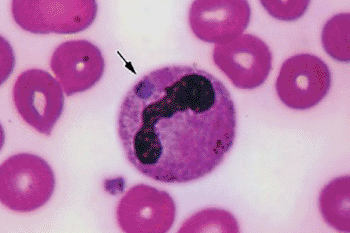
Anaplasmosis granulocitotrópica de seres humanos

La Anaplasmosis Granulocitotrópica, también conocida como HGA por sus siglas en inglés (Human Granulocytic Anaplasmosis), es una enfermedad infecciosa causada por la bacteria Anaplasma phagocytophilum. Esta bacteria afecta principalmente a los granulocitos, un tipo de glóbulo blanco presente en la sangre, y se transmite a los humanos a través de la picadura de garrapatas infectadas, principalmente del género Ixodes.
Epidemiología
Se habían notificado casos de Anaplasmosis Granulocitotrópica (HGA) siendo muchos de estos casos provenientes de estados del medio oeste y el noreste. La distribución geográfica de la enfermedad es similar a la de la enfermedad de Lyme, ya que comparten la misma garrapata vectora, Ixodes.
En Estados Unidos, los ratones de patas blancas, las ardillas y el venado cola blanca, así como en Europa, el venado rojo, actúan como reservorios naturales de A. phagocytophilum, el agente causal de la HGA.
La incidencia de la HGA alcanza su punto máximo de mayo a julio, pero la enfermedad puede surgir en cualquier mes del año después de la exposición a las garrapatas Ixodes.
La HGA tiende a afectar más a varones (59%) y a adultos mayores, con una mediana de edad de 51 años.
Manifestaciones clínicas de la Anaplasmosis granulocitotrópica
La frecuencia serológica adquiere importancia en regiones endémicas, ya que es posible que muchos individuos presenten infecciones subclínicas de Anaplasmosis Granulocitotrópica (HGA).
El periodo de incubación de la HGA es de cuatro a ocho días, tras los cuales la enfermedad se manifiesta con fiebre (75% a 100% de los casos), mialgias (73%), cefalea (82%), y malestar general (97%). Algunos pacientes pueden experimentar síntomas gastrointestinales como náusea, vómito o diarrea (20% a 40%), así como tos (27%) o confusión (17%).
Cabe destacar que casi invariablemente, el exantema (5%) asociado a la HGA es un eritema migratorio confluente, que puede atribuirse erróneamente a la enfermedad de Lyme.
En el ámbito hematológico, muchas personas afectadas presentan trombocitopenia (80%) o leucopenia (63%), acompañadas por un aumento en la actividad de aminotransferasa hepática en suero (80%).
Complicaciones
Las complicaciones que representan un riesgo para la vida son más comunes en personas de edad avanzada e incluyen problemas como insuficiencia renal, síndrome de dificultad respiratoria del adulto, un cuadro similar al choque tóxico, neumonía y un síndrome parecido a la coagulación intravascular diseminada (DIC) o septicemia. Aunque la meningoencefalitis en la Anaplasmosis Granulocitotrópica (HGA) es rara, se han registrado casos de afectación de nervios periféricos como la plexopatía braquial, lesiones en nervios craneales y polineuropatía desmielinizante. La infección en pacientes con condiciones inmunodepresoras preexistentes, como diabetes, uso de medicamentos inmunosupresores, ausencia de bazo o artritis, se relaciona con un riesgo relativo de 3.0 para complicaciones graves.
En cuanto a los pacientes con HGA, el 31% requiere hospitalización, y el 7% necesita cuidados intensivos. Aunque la tasa de letalidad por casos es del 0.3%, el riesgo relativo de muerte se eleva a 16 en presencia de un trastorno inmunosupresor. Es relevante destacar que la vasculitis y los granulomas no son parte de la HGA. Aunque los pacientes pueden contraer simultáneamente Borrelia burgdorferi y Babesia microti (transmitidas por la misma garrapata vectora), hay escasa evidencia de que la gravedad de estas infecciones aumente o de que la HGA persista. La transmisión de la HGA por transfusión, incluyendo la transfusión de sangre con reducción de leucocitos o plaquetas, ya se ha documentado.
Diagnóstico
Diagnóstico Diferencial: Es esencial considerar enfermedades que presenten síntomas similares a la gripe en el diagnóstico diferencial, especialmente durante las estaciones de actividad de la garrapata Ixodes (de mayo a diciembre), especialmente después de picaduras o exposición a garrapatas.
Marcadores Coincidentes: La presencia simultánea de trombocitopenia, leucopenia o el aumento de los niveles séricos de aminotransferasa de alanina o aspartato incrementa la probabilidad de Anaplasmosis Granulocitotrópica (HGA). En casos de HGA, algunas personas generan anticuerpos contra el microorganismo de la enfermedad de Lyme sin manifestar signos clínicos compatibles con dicha enfermedad.
Consideración de la HGA: La HGA debe ser considerada en el diagnóstico diferencial de cualquier sintomatología atípica asociada con la enfermedad grave de Lyme.
Confirmación del Diagnóstico: En un rango del 20% al 75% de las infecciones, el diagnóstico puede confirmarse observando mórulas y neutrófilos en un frotis de sangre periférica.
Técnica de PCR: La práctica de la reacción en cadena de la polimerasa (PCR) en la sangre de individuos con la enfermedad activa antes de recibir doxiciclina es una técnica sensible y específica.
Diagnóstico Serológico: El diagnóstico serológico tiene un carácter retrospectivo y requiere demostrar un aumento cuádruple en la cuantificación de anticuerpos contra A. phagocytophilum (hasta ≥ 128) en pares de muestras de suero obtenidas con una diferencia de 1 mes. Dada la alta seroprevalencia en ciertas regiones, no se debe depender de una sola cuantificación durante la fase aguda para establecer el diagnóstico.
Tratamiento y Pronóstico
La doxiciclina, administrada a una dosis de 100 mg por vía oral dos veces al día, ha demostrado ser un tratamiento eficaz para la Anaplasmosis Granulocitotrópica (HGA), contribuyendo significativamente a la mejoría de los síntomas y formando parte integral del manejo de la infección. En casos específicos, como en mujeres embarazadas y niños, el uso de rifampicina también se ha asociado con mejoras en la condición de los pacientes afectados por la enfermedad.
Un aspecto destacado del tratamiento es la rápida defervescencia observada en muchos pacientes tratados, evidenciando una disminución de la fiebre en un periodo de 24 a 48 horas después de iniciar la terapia. Esta pronta respuesta subraya la efectividad de las estrategias terapéuticas empleadas.
En términos de prevención, se enfatiza la importancia de evitar el contacto con garrapatas, ya que estas son los vectores de transmisión de la HGA. Medidas preventivas, como el uso de ropa protectora y repelentes de insectos, son cruciales para reducir el riesgo de adquirir la infección.
Es relevante destacar que la transmisión de la HGA puede confirmarse de manera rápida, incluso apenas 4 horas después de la picadura de la garrapata. Este breve periodo subraya la prontitud con la que la infección puede establecerse después del contacto con el insecto vector.
.


